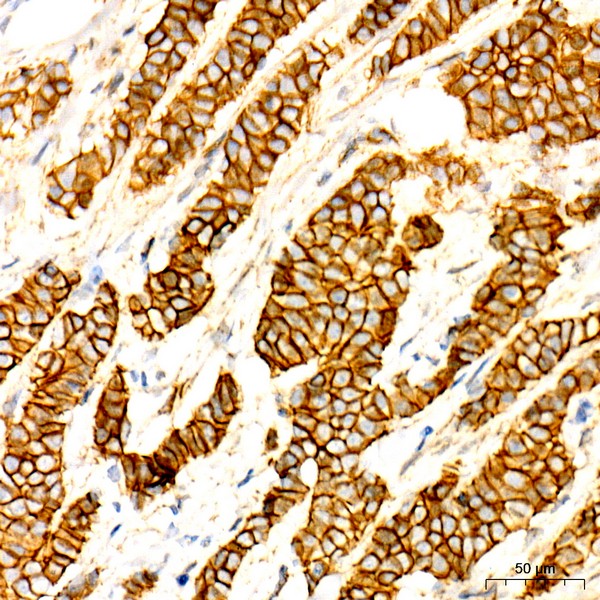
Non-phospho (Active)β-Catenin -S33/S37/T41 Rabbit mAb (Catalog Number: A22180) Abclonal
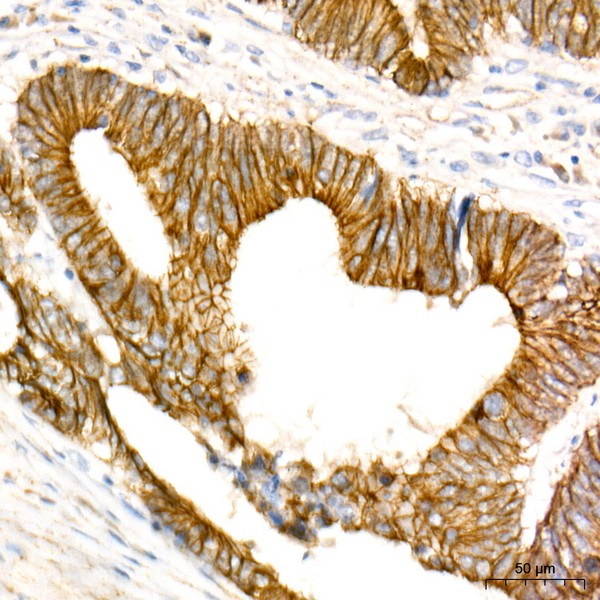
Abclonal Non-phospho (Active)β-Catenin -S33/S37/T41 Rabbit mAb (Catalog Number: A22180)

Non-phospho (Active)β-Catenin -S33/S37/T41 Rabbit mAb (A22180)
$148.00 – $548.00
Abclonal Non-phospho (Active)β-Catenin -S33/S37/T41 Rabbit mAb (Catalog Number: A22180) encoded by this gene is part of a complex of proteins that constitute adherens junctions (AJs). AJs are necessary for the creation and maintenance of epithelial cell layers by regulating cell growth and adhesion between cells.
- Details & Specifications
- References
| Catalog No. | A22180 |
|---|---|
| Product Name | Non-phospho (Active)β-Catenin -S33/S37/T41 Rabbit mAb (A22180) |
| Supplier Name | ABclonal, Inc. |
| Brand Name | Abclonal |
| Synonyms | EVR7; CTNNB; MRD19; NEDSDV; armadillo |
| Gene Name | CTNNB1 |
| Protein Name | CTNNB1 |
| Uniprot/Swissprot ID | P35222 |
| Gene ID | 1499 |
| Clone | ARC53641 |
| Clonality | Monoclonal |
| Source/Host | Rabbit |
| Reactivity | Human, Mouse, Rat |
| Conjugate | Unconjugated |
| Note | Products will be shipped from the warehouse in Massachusetts. Promotion is running from time to time. Welcome to send a request for quote to message@sydlabs.com. |
| Order Offline | Syd Labs, Inc. 4 Avenue E, Hopkinton, MA 01748 USA. Phone: 1-617-401-8149 Fax: 1-617-606-5019 Email: message@sydlabs.com |
Description
A22180: Non-phospho (Active)β-Catenin -S33/S37/T41 Rabbit mAb
The protein encoded by this gene is part of a complex of proteins that constitute adherens junctions (AJs). AJs are necessary for the creation and maintenance of epithelial cell layers by regulating cell growth and adhesion between cells. The encoded protein also anchors the actin cytoskeleton and may be responsible for transmitting the contact inhibition signal that causes cells to stop dividing once the epithelial sheet is complete. Finally, this protein binds to the product of the APC gene, which is mutated in adenomatous polyposis of the colon. Mutations in this gene are a cause of colorectal cancer (CRC), pilomatrixoma (PTR), medulloblastoma (MDB), and ovarian cancer. Alternative splicing results in multiple transcript variants.
Immunogen Information about Non-phospho (Active)β-Catenin -S33/S37/T41 Rabbit mAb (A22180)
Immunogen:A synthetic peptide corresponding to a sequence within amino acids 1-100 of human Non-phospho (Active)β-Catenin -S33/S37/T41 (NP_001895.1).
Sequence:MATQADLMELDMAMEPDRKAAVSHWQQQSYLDSGIHSGATTTAPSLSGKGNPEEEDVDTSQVLYEWEQGFSQSFTQEQVADIDGQYAMTRAQRVRAAMFP
Gene ID:1499
Swiss prot:P35222
Synonyms:EVR7; CTNNB; MRD19; NEDSDV; armadillo; Non-phospho (Active)β-Catenin -S33/S37/T41
Calculated MW:85kDa
Observed MW:92kDa
Images of Non-phospho (Active)β-Catenin -S33/S37/T41 Rabbit mAb (A22180)

Western blot analysis of extracts of various lysates, using Non-phospho (Active)β-Catenin -S33/S37/T41 antibody (A22180) at 1:20000 dilution.
Secondary antibody: HRP Goat Anti-Rabbit IgG (H+L) (AS014) at 1:10000 dilution.
Lysates/proteins: 25μg per lane.
Blocking buffer: 3% nonfat dry milk in TBST.
Detection: ECL Basic Kit (RM00020).
Exposure time: 180s.

Western blot analysis of extracts of HeLa, using Non-phospho (Active)β-Catenin -S33/S37/T41 antibody (A22180) at 1:20000 dilution.
Secondary antibody: HRP Goat Anti-Rabbit IgG (H+L) (AS014) at 1:10000 dilution.
Lysates/proteins: 25μg per lane.
Blocking buffer: 3% nonfat dry milk in TBST.
Detection: ECL Enhanced Kit (RM00021).
Exposure time: 180s.

Immunohistochemistry analysis of paraffin-embedded human breast cancer using Non-phospho (Active)β-Catenin -S33/S37/T41 Rabbit mAb (A22180) at dilution of 1:100 (40x lens).Perform high pressure antigen retrieval with 10 mM citrate buffer pH 6.0 before commencing with IHC staining protocol.

Immunohistochemistry analysis of paraffin-embedded human colon carcinoma using Non-phospho (Active)β-Catenin -S33/S37/T41 Rabbit mAb (A22180) at dilution of 1:100 (40x lens).Perform high pressure antigen retrieval with 10 mM citrate buffer pH 6.0 before commencing with IHC staining protocol.

Immunohistochemistry analysis of paraffin-embedded human tonsil using Non-phospho (Active)β-Catenin -S33/S37/T41 Rabbit mAb (A22180) at dilution of 1:100 (40x lens).Perform high pressure antigen retrieval with 10 mM citrate buffer pH 6.0 before commencing with IHC staining protocol.
Please remember our product information: Non-phospho (Active)β-Catenin -S33/S37/T41 Rabbit mAb (Catalog Number: A22180) Abclonal